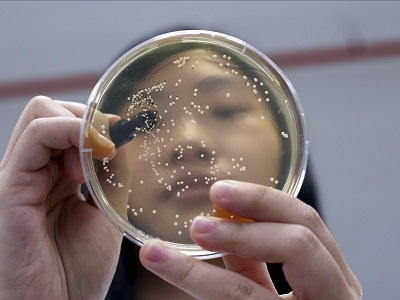
أحد مختبرات التكنولوجيا الحيوية في سنغافورة

سيدة تبتعد ويظهر خلفها شريحة عرض لمخ الإنسان
الإبتكارات من أكثر الأشياء إثارة وهي التي تدفع الأمم الي طريق التقدم.
لكي تضع الدولة نفسها علي مسار الإبتكارات والإختراعات هناك الكثير من الخطوات يجب القيام بها ، فيجب عليها أن تهيئ البيئة العلمية للأبتكار وذلك بدعم من مؤسسات الدولة ومن شركات القطاع الخاص.
نحن نتحدث علي وجه الخصوص عن وجود مؤسسات للبحث العلمي وتوفير الأستثمارات اللازمة للأبحاث والتطوير وحماية الملكية الفكرية.
سوف نلقي نظرة علي تقرير أعده المنتدي العالمي للأقتصاد World Economic Forum والذي يقيم أداء أفضل 12 دولة في العالم في مجال الإبتكارات والتي حققت نجاحا متميزا في مجال البحث العلمي والإختراع لتساهم في تقدم البشرية.
12- بريطانيا

مارك سيمز مدير مهمة بيجل 2 السفينة الفضائية التي أطلقتها وكالة الفضاء الأوربية
وضع المنتدي العالمي للأقتصاد مجموعة من المعايير لتحديد ترتيب الدول في مجال الإبتكار، وقد أحتلت بريطانيا المركز الثاني في معيار كفاءة مؤسسات البحث العلمي.
كما حققت المركز الرابع في مجال تعاون الجامعات مع القطاع الصناعي في الأبحاث والتطوير.
ولكنها حققت المركز 34 في مجال مشتريات الحكومة من التكنولوجيا والمنتجات الحديثة. وأحتلت المركز 18 في معيار توفر العلماء والمهندسين للبحث العلمي.
التقرير يثني علي بريطانيا في تحقيقها تطورا كبيرا في مجال الخدمات حتي أصبحت مركزا أوربيا هاما في مجال التكنولوجيا.
11- تايوان

تتميز تايوان بالإبتكارات في مجال تكنولوجيا الحاسبات والتابلت والألعاب الإلكترونية
حققت تايوان المركز 13 في معاير إنفاق الشركات علي الأبحاث والتطوير، كما حققت المركز 14 في التعاون بين الجامعات والقطاع الصناعي في مجال الأبحاث.
أما في معيار شراء المؤسسات الحكومية للإبتكارات والمنتجات التكنولوجية الحديثة فقد أحتلت المركز 29 وفي مجال جودة مؤسسات البحث العلمي أحتلت المركز 26 عالميا.
رغم أن تايوان قد إنخفض ترتيبها بمقدار درجة واحدة في معيار التنافسية العالمية إلا أن المشكلة الحقيقية لهذه الدولة الصغيرة هو عدم كفاية الإمكانيات اللازمة لتحقيق مزيد من الإختراعات وفقا لتقرير المنتدي الإقتصادي العالمي.
10- الدنمارك

رائد الفضاء الدنماركي أندرياس موجنسن
تحتل الدنمارك المركز الثامن في معيار عدد براءات الإختراع مقارنة مع عدد السكان. وهي في المركز 11 في معيار القدرات الضرورية لتعزيز الإبتكار والإختراع.
ولكنها سجلت مركزا متأخرا وهو 65 في معيار المشتريات الحكومية من التكنولوجيا الحديثة والمنتجات المبتكرة. والمركز 35 في توفر العلماء والباحثين لمجال البحث العلمي.
الذي ساعد الدنمارك علي احتلال هذا المركز في التقرير هو معدل الإختراعات العالي مقارنة مع حجم أقتصادها.
9- سنغافورة
أحد مختبرات التكنولوجيا الحيوية في سنغافورة
تحتل سنغافورة المركز الرابع في معيار شراء المؤسسات الحكومية للتكنولوجيا الحديثة والمنتجات المبتكرة. كما تحتل المركز الخامس في التعاون بين الجامعات والمؤسسات الصناعية في مجال الأبحاث والتطوير.
أما في معيار توفر الأمكانيات اللازمة لعملية الإبتكار فهي تحتل المركز 19.
يشير التقرير أن سنغافورة لديها أفضل نظام للتعليم والتدريب في العالم وهو أهم ميزة وضعت سنغافورة ضمن قائمة العشرة الأوائل.
كما تحتل سنغافورة مركز متقدم في احتضان التكنولوجيا الجديدة والإختراعات ونظم الأعمال الحديثة.
8- هولندا

منتجات تم إعدادها بتكنولوجيا الطباعة ثلاثية الأبعاد في أحد المراكز بأمستردام
حصلت هولندا علي المركز السادس في كفاءة مؤسسات البحث العلمي. وأحتلت المركز التاسع في معيار تعاون الجامعات مع القطاع الصناعي في الأبحاث والتطوير.
وأحتلت المركز 22 في معيار توفر العلماء والمهندسين للبحث العلمي. أما في مجال المشتريات الحكومية من التكنولوجيا الحديثة فقد أحتلت المركز 21 عالميا.
يشير التقرير الي أن الأقتضاد الهولندي هو واحدا من أكثر الأقتصاديات العالمية تطورا وتعقيدا في نفس الوقت مع سوق مفتوحة ومتميزة لمختلف المنتجات.
7- السويد

مركز شركة إيركسون في ستوكهولم
تحتل السويد المركز الثالث عالميا في معيار النسبة بين براءات الإختراع مع عدد السكان. كما تحتل المركز الرابع في القدرات اللازمة لعملية الإبتكار.
لكن في معيار شراء المؤسسات الحكومية للمنتجات الإلكترونية الحديثة فتحتل هولند المركز 23 عالميا، أما في مجال توفر الباحثين والعلماء والمهندسين للبحث العلمي فتحتل المركز 14 وفقا للتقرير.
توفر السويد البيئة التكنولوجية اللازمة للإبتكار من حيث استخدام الكمبيوتر والإنترنت علي نظاق واسع، كما أن القطاع الخاص يمتاز أيضا بالتطور التكنولوجي.
6- ألمانيا

أحد مراكز الأبحاث الزراعية في ميونخ والتي تعني بإنتاج صحي قريب من كل مواطن
تحتل ألمانيا المركز الخامس في معيار توفر الإمكانيات اللازمة للأبتكار. كما تحتل المركز السادس في إنفاق الشركات الصناعية علي الأبحاث والتطوير.
المعيار الوحيد الذي لم تحتل فيه ألمانيا أحد المركز العشرة الأولي هو توفر الباحثين والمهندسين للبحث العلمي حيث أحتلت المركز 15.
يشير التقرير أن النظام الألماني يعتمد بدرجة كبيرة علي الإنفاق العالي للشركات الألمانية في مجال الأبحاث والتطوير، ودعم بيئة البحث العلمي، والتعاون الوثيق بين قطاع الأعمال والجامعات ومراكز البحث.
5- اليابان

الروبوت روبي طوله 35 سم ويستطيع المشي والكلام والرقص وهو من إنتاج شركة توموتاكا
تحتل اليابان المركز الأول عالميا في معيار النسبة بين براءات الاختراع مقارنة مع عدد السكان. كما يحتل المركز الثاني في إنفاق الشركات علي التطوير والأختراع.
أما في معيار التعاون بين الجامعات والقطاع الصناعي فتحتل المركز 16 وفي معيار توفير البيئة المناسبة للأبتكار فتحتل اليابان المركز 14 عالميا.
يقول التقرر أن المستوي العالمي لمراكز البحث العلمي اليابانية والمعدل العالي لأنفاق الشركات علي مراكز أبحاثها مع توفر الباحثين والمهندسين الذين يتميزون بالكفاءة العالية تتواكب مع المناخ العام في الدولة الذي يدفع للابتكار والتميز.
4- الولايات المتحدة

تتميز الولايات المتحدة بمستوي طبي عالي وبيئة تدفع علي الإبتكار
تحتل الولايات المتحدة المركز الثاني عالميا في توفير البيئة المناسبة للابتكار. كما تتميز بمستوي عالي للجامعات ومراكز الأبحاث مما وضعها في المركز الثاني عالميا في مجال التعاون بين الجامعات وقطاع الصناعة والأعمال.
أما في مجال مشتريات الحكومة للتكنولوجيا الحديثة فتحتل المركز 11 عالميا.
يقول التقرير أن أهم ما يميز الولايات المتحدة في توفر بيئة وفدرات عالية للأبتكار مع سوق كبيرة تستطيع أن تدفع المنتجات الحديثة الي النجاح في وقت قصير.
كما يوضح التقرير التميز في تعاون الجامعات مع قطاع الأعمال وتوفر العنصر البشري القوي.
3- إسرائيل

مركز للأبحاث العسكرية الإلكترونية يطور مجموعة حساسات توضع علي جسم الطيارين لقياس الوظائف الحيوية
تحتل إسرائيل أحد المراكز العشر الأولي في كل المعايير التي ذكرها التقرير.
تحتل المركز الثالث في توفير البيئة والقدرات اللازمة للأبتكار، كما تحتل المركز الثالث في جودة المراكز البحثية.
أما المعيار الذي حققت فيه مركز أقل فهو توفر الباحثين والمهندسين حيث تحتل المركز الثامن، وفي معيار شراء الحكومة للمنتجات التكنولوجية الحديثة فهي تحتل المركز التاسع.
وفقا لمعيار التنافسية العالمية تحظي إسرائيل بالمركز الـ 27 عالميا، وذلك بسبب التقدم التكنولوجي الذي يدفع أقتصادها للأمام.
2- فنلندا

سبستيان نستروم رئيس المنتجات بشركة نوكيا
تحتل فنلندا المركز الأول في معيار توفر الباحثين والمهندسين اللازمين لعمليات الإبتكار، كما تحتل أيضا المركز الأول في تعاون الجامعات ومراكز الأبحاث مع الشركات الصناعية وقطاع الأعمال بشكل عام.
المعيار الوحيد الذي لم تتواجد فيه فنلندا في المراكز العشر الأولي كان مشتريات المؤسسات الحكومية من المنتجات التكنولوجية الحديثة حيث أحتلت المركز 33.
تمتاز المؤسسات العامة في فنلندا بالشفافية وارتفاع مستوي الكفاءة. أما مستوي التعليم والتدريب فهو في الصف الأول عالميا أما قطاع الأعمال فهو الأكثر إبتكارية في العالم.
1- سويسرا

مصادم هادرون الكبير ، اكبر و اقوى مصادم الجسيمات في العالم ، يقع بالقرب من جنيف
سجلت سويسرا المركز الأول عالميا في ثلاث من المعايير التي أشار إليها التقرير وهي، توفر القدرات لعمليات الإبتكار وعلماء وباحثين ومهندسين علي أعلي مستوي لعمليات الأبحاث والإبتكار، وإنفاق الشركات الكبير علي عمليات التطوير والإبتكار.
لكن نقطة الضعف في سويسرا هي في عدم توفر العدد الكافي من الباحثين والمهندسين رغم أرتفاع مستواهم.
يشير التقرير الي أن سويسرا تقود عمليات الإبتكار في العالم وهي تمتلك معهد “سرن” للأبحاث النووية أحد أبرز مراكز الأبحاث في العالم.

